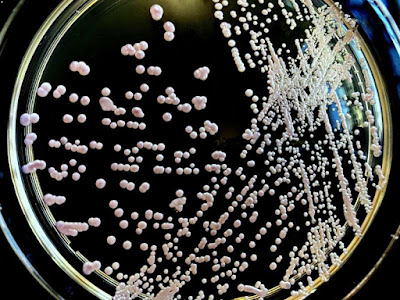

Não é para menos. Além de causar uma infecção grave, muitas vezes fatal – especialmente se entrar na corrente sanguínea – o C.auris é multirresistente a vários medicamentos antifúngicos comumente usados para tratar infecções por Candida. Algumas cepas são resistentes a todas as três classes disponíveis de antifúngicos. Isso acontece porque os microrganismos têm evoluído e se tornado mais fortes para conseguirem sobreviver.
Outro fator complicador é que esse fungo é difícil de ser identificado com métodos de laboratório padrão.
No fim do ano passado, o Brasil identificou o primeiro caso de C. auris em um paciente de um hospital privado de Salvador. Foram realizadas duas contraprovas, sendo uma no Laboratório Central de Saúde Pública da Bahia (Lacen-BA) e outra na Universidade de São Paulo, que é a referência nacional do Ministério da Saúde, testando positivo em todas as ocasiões.
O caso levou a Agência Nacional de Vigilância Sanitária (Anvisa) a emitir um alerta e organizar uma força-tarefa nacional para acompanhar o micro-organismo, que costuma se espalhar e causar surtos em ambientes hospitalares.
O que é Candida auris e como acontece a transmissão?
O Candida auris é uma espécie de fungo que cresce como levedura. Foi catalogado pela primeira vez ao ser encontrado no canal auditivo de um paciente na Coreia do Sul, em 2009. Desde então, houve casos identificados em mais de 30 países como Estados Unidos, Índia, Inglaterra, África do Sul, Venezuela, Colômbia, Israel, Paquistão, Quênia, Kuwait, Reino Unido e Espanha, além do Brasil.
A epidemiologista Johanna Rhodes, do Imperial College London, que ajudou a combater um surto de Candida auris na Inglaterra em 2016, chama atenção para outra característica ainda mais impressionante do fungo. “Uma das coisas que tornam o Candida auris tão assustador é o fato de que ele pode permanecer em superfícies inanimadas por longos períodos e suportar o que quer que você jogue nela”, disse ela à New Scientist.
Algumas pesquisas já constataram que diversos desinfetantes, entre os quais, os que são à base de quartenário de amônio não são capazes de matar o fungo. É por essa e outras razões que os cientistas têm tratado o C. auris como o “patógeno quase perfeito”.
Quem corre mais risco?
De acordo com a infectologista Thais Brito, o vírus representa maior risco a pacientes hospitalizados com o sistema imunológico comprometido ou internados em unidades de terapia intensiva que fazem uso de cateteres vasculares e sondas.
“O modo exato de transmissão não é totalmente conhecido, mas há evidências de que isso aconteça através do contato pessoa a pessoa e também por meio do contato prolongado com superfícies ou dispositivos médicos contaminadas pelo fungo”, explica a infectologista. No caso da Bahia, o C. auris só foi descoberto depois que traços do fungo foram identificados na ponta de um cateter inserido no paciente internado com covid-19.
Para os especialistas, é fundamental desenvolver armas melhores contra inimigos como Candida auris agora, antes que se tornem a próxima pandemia. “Precisamos investir mais em pesquisa e desenvolvimento e preparar nossas defesas – contra todos os tipos de patógenos infecciosos”, disse Mahmoud Ghannoum, especialista em doenças fúngicas da Case Western Reserve University em Ohio.
Sem comentários:
Enviar um comentário